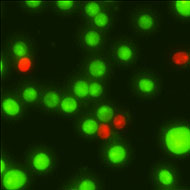

碧云天AO/PI双染试剂盒(Set A, 细胞计数仪专用) (C2019A)对BGC-823细胞染色的效果图:

图A为荧光效果图,绿色荧光表示活细胞,红色荧光表示死细胞;
图B为明场图,绿圈为活细胞,红圈为死细胞,均为细胞计数仪自动识别。
碧云天AO/PI细胞活性检测试剂盒(荧光显微镜专用) (C2017)对HeLa细胞染色的效果图:
图中绿色荧光表示活细胞,红色荧光表示坏死细胞
以上效果图中,均为细胞计数仪自动识别,一眼就能分辨活细胞和死细胞,轻松完成对细胞准确计数。
这就是碧云天的AO/PI双染试剂盒,本系列产品共5款产品可选,适用于多数仪器,还可根据不同细胞计数仪自行测试染料用量,让细胞计数更精准。
AO/PI双染试剂盒
碧云天生产的AO/PI双染试剂盒是由吖啶橙(AO)染色液和碘化丙锭(PI)染色液优化比例混合而成,基于DNA探针双染细胞核,快速、便捷检测细胞活性的试剂盒。
本系列产品针对不同荧光强度的荧光细胞计数仪,推出Set A、Set B、Set C和测试装四款细胞计数仪专用以及一款荧光显微镜专用,共五款产品。应该选择哪款呢?请看选购指南
选购指南
Set A、Set B和Set C三种试剂盒的绿色荧光由弱到强,Set A荧光相对最弱一点,Set C荧光相对强一点,初次选购可以考虑尝试Set B(C2019B);
如果以上3个产品都不太适合该荧光细胞计数仪,可以选购测试装(C2021)自行测试适当的荧光染料用量,后续如有需要可以联系碧云天进行定制;
如果需要使用荧光显微镜观察计数效果,可以选购荧光显微镜专用(C2017)。
产品原理
AO是经典的、极灵敏的特异染性荧光染料,能透过细胞膜,使DNA和RNA染色。在正常细胞中,细胞核呈绿色或黄绿色均匀荧光;在凋亡细胞中,细胞呈现黄绿色荧光或黄绿色碎片颗粒;在坏死细胞中,黄荧光减弱甚至消失。
PI是一种非细胞膜通透性荧光染料,不能穿过具有生物活性的细胞质膜,只能对于坏死细胞因为其细胞膜缺乏完整性而能到达细胞核,只能染色死细胞,呈现红色荧光。
用本试剂盒对细胞染色后,绿色荧光表示活细胞,红色荧光表示死细胞。
产品特点
- 操作简单:提供即用型的AO/PI双染试剂,使用时,仅需按照1:1的比例与细胞样品混合即可;
- 检测精度高,染色速度快:无需制备和稀释各种溶液的繁琐过程,免去制备和稀释过程中可能产生的误差,提高了检测的精确度,整个染色过程5分钟内可完成;
- 产品丰富,选择多样:本系列产品根据其染色的强度分为Set A、Set B、Set C三个产品,绿色荧光的染色强度依次增强,适用于多种细胞计数仪,用户可根据实验所用的细胞计数仪的特性进行选择。
产品信息
| 产品编号 | 产品名称 | 包装 | 产品价格 |
| C2019A-1ml | AO/PI双染试剂盒(Set A, 细胞计数仪专用) | 100次 | |
| C2019A-5ml | AO/PI双染试剂盒(Set A, 细胞计数仪专用) | 500次 | |
| C2019B-1ml | AO/PI双染试剂盒(Set B, 细胞计数仪专用) | 100次 | |
| C2019B-5ml | AO/PI双染试剂盒(Set B, 细胞计数仪专用) | 500次 | |
| C2019C-1ml | AO/PI双染试剂盒(Set C, 细胞计数仪专用) | 100次 | |
| C2019C-5ml | AO/PI双染试剂盒(Set C, 细胞计数仪专用) | 500次 | |
| C2017S | AO/PI细胞活性检测试剂盒(荧光显微镜专用) | 50次 | |
| C2017M | AO/PI细胞活性检测试剂盒(荧光显微镜专用) | 250次 | |
| C2021S | AO/PI双染试剂盒(测试装, 细胞计数仪专用) | 4×1ml |
相关产品
| 产品编号 | 产品名称 | 包装 | 产品价格 |
| C0011 | 台盼蓝染色细胞存活率检测试剂盒 | 100次 | |
| C0233S | 吖啶橙染色试剂盒 | 100-1000次 | |
| C0233M | 吖啶橙染色试剂盒 | 500-5000次 | |
| C1313-1ml | 台盼蓝染色液(2X, 细胞计数仪专用) | 1ml | |
| C1313-5ml | 台盼蓝染色液(2X, 细胞计数仪专用) | 5ml | |
| C1313-25ml | 台盼蓝染色液(2X, 细胞计数仪专用) | 25ml | |
| C2013S | Calcein AM细胞活性检测试剂盒(CCK-F) | 100次 | |
| C2013M | Calcein AM细胞活性检测试剂盒(CCK-F) | 500次 | |
| C2013L | Calcein AM细胞活性检测试剂盒(CCK-F) | 2500次 | |
| C2015S | Calcein/PI细胞活性与细胞毒性检测试剂盒 | 100次 | |
| C2015M | Calcein/PI细胞活性与细胞毒性检测试剂盒 | 500次 | |
| C2015L | Calcein/PI细胞活性与细胞毒性检测试剂盒 | 2500次 | |
| C2030S | 细菌死活染色试剂盒(DMAO/PI) | 200次 | |
| C2030M | 细菌死活染色试剂盒(DMAO/PI) | 1000次 | |
| C1181S | 死细胞绿色荧光染色试剂盒(Nuclear Green) | 1000次 | |
| C1186-100ml | 细胞核绿色荧光染色液(Nuclear Green) | 100ml | |
| C1075S | YO-PRO-1/PI细胞凋亡与坏死检测试剂盒 | 100次 | |
| C1075M | YO-PRO-1/PI细胞凋亡与坏死检测试剂盒 | 500次 | |
| ST511 | Propidium Iodide/碘化丙啶 | 5mg | |
| ST512 | Propidium Iodide/碘化丙啶 | 20mg | |
| C2012-0.1ml | Calcein AM (钙黄绿素AM) | 2mM×0.1ml | |
| C2012-0.5ml | Calcein AM (钙黄绿素AM) | 2mM×0.5ml |
